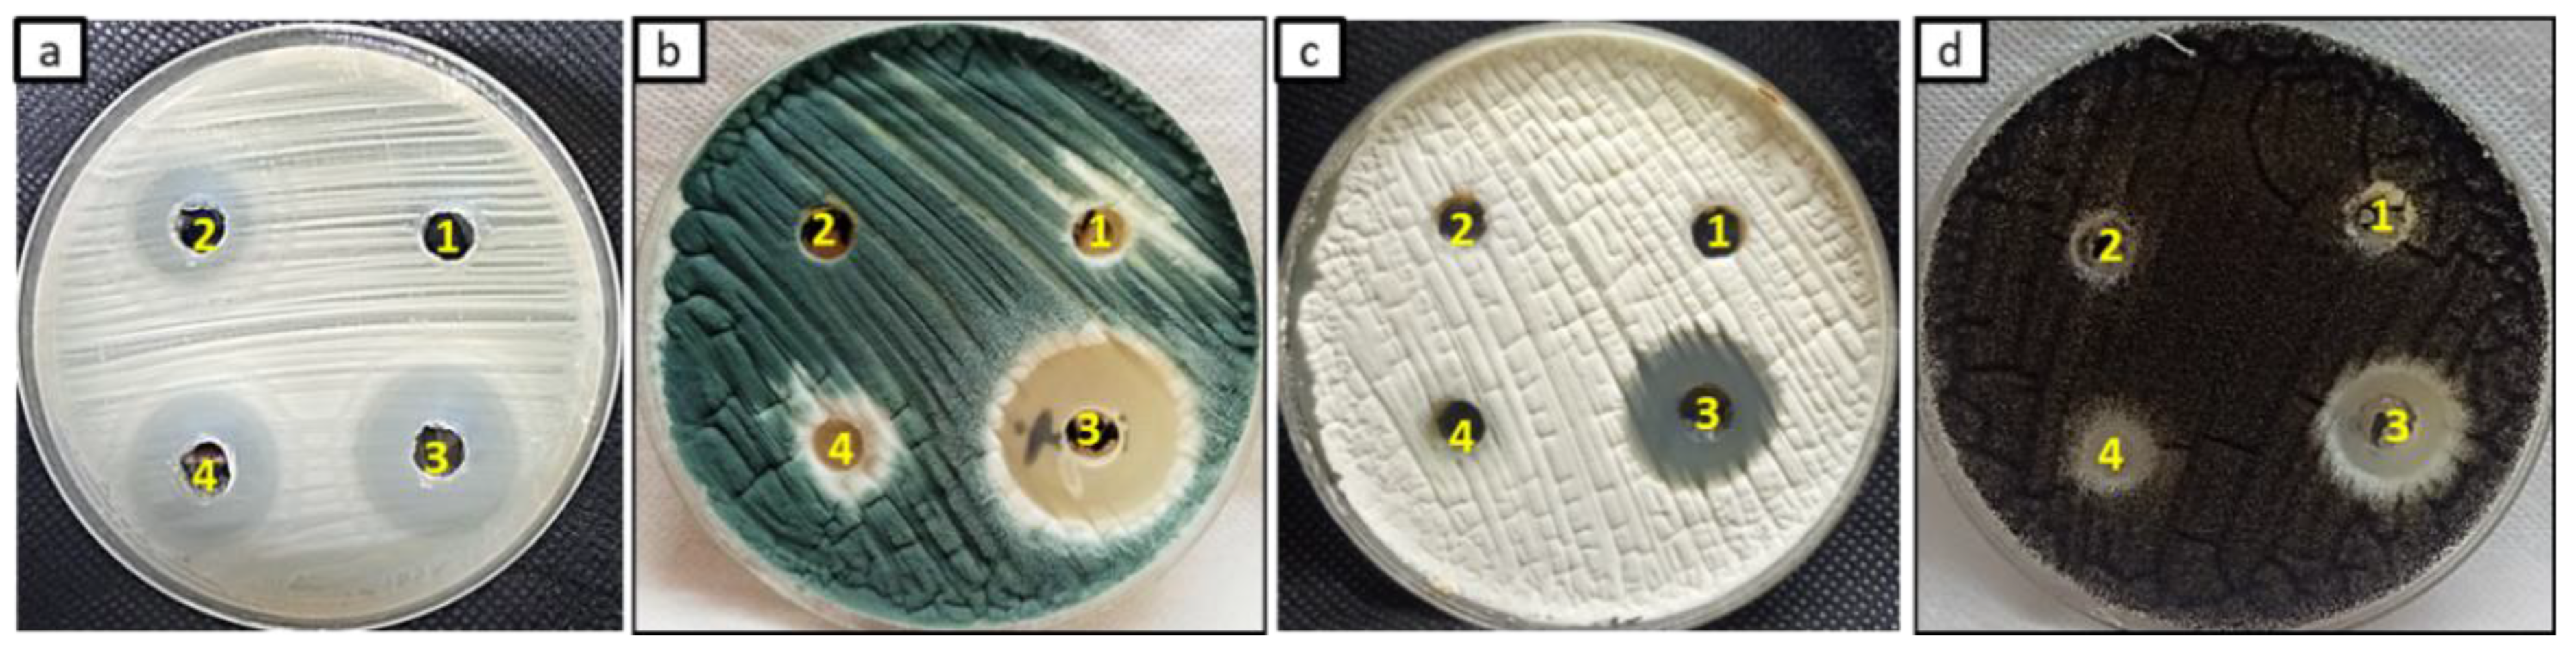
Jof 08 00612 g006 550

Multifunctional Silver Nanoparticles Based on Chitosan: Antibacterial, Antibiofilm, Antifungal, Antioxidant, and Wound-Healing Activities
Abstract
:1. Introduction
2. Materials and Methods
2.1. Synthesis of Chitosan/Silver Nanoparticles (Chi/Ag-NPs)
2.2. Characterization of Chi/Ag-NPs
2.3. Microbial Strains and Reagent
2.4. Broth Microdilution Assay
2.5. Evaluation of Anti-Biofilm Activity
2.6. Antifungal Activity
2.7. Antioxidant Activity
2.8. Determination of Safe Dose on the Proliferation of Normal Human Skin Fibroblast Cell Line by Sulphorhodamine B (SRB) Assay
2.9. In Vitro Wound-Healing Assay
2.10. Statistical Analysis
3. Results and Discussion
3.1. Characterization of Chi/Ag-NPs
3.2. Determination of Minimum Inhibitory Concentration (MIC) by Resazurin Stain
3.3. Anti-Biofilm Evaluation
3.4. Antifungal Activity
3.5. Antioxidant Activity
3.6. Cytotoxicity on Normal Human Skin Cell Line (BJ-1)
3.7. Cell Migration Assay (Wound Scratch Assay)
4. Conclusions
Author Contributions
Funding
Institutional Review Board Statement
Informed Consent Statement
Data Availability Statement
Acknowledgments
Conflicts of Interest
References
- Mitchell, M.J.; Billingsley, M.M.; Haley, R.M.; Wechsler, M.E.; Peppas, N.A.; Langer, R. Engineering precision nanoparticles for drug delivery. Nat. Rev. Drug Discov. 2021, 20, 101–124. [Google Scholar] [CrossRef] [PubMed]
- Shehabeldine, A.M.; Hashem, A.H.; Wassel, A.R.; Hasanin, M. Antimicrobial and antiviral activities of durable cotton fabrics treated with nanocomposite based on zinc oxide nanoparticles, acyclovir, nanochitosan, and clove oil. Appl. Biochem. Biotechnol. 2021, 194, 783–800. [Google Scholar] [CrossRef] [PubMed]
- Salem, S.S.; Hammad, E.N.; Mohamed, A.A.; El-Dougdoug, W. A Comprehensive Review of Nanomaterials: Types, Synthesis, Characterization, and Applications. Biointerface Res. Appl. Chem. 2023, 13, 14. [Google Scholar] [CrossRef]
- Aref, M.S.; Salem, S.S. Bio-callus synthesis of silver nanoparticles, characterization, and antibacterial activities via Cinnamomum camphora callus culture. Biocatal. Agric. Biotechnol. 2020, 27, 101689. [Google Scholar] [CrossRef]
- Salem, S.S.; Ali, O.M.; Reyad, A.M.; Abd-Elsalam, K.A.; Hashem, A.H. Pseudomonas indica-Mediated Silver Nanoparticles: Antifungal and Antioxidant Biogenic Tool for Suppressing Mucormycosis Fungi. J. Fungi 2022, 8, 126. [Google Scholar] [CrossRef]
- Salem, S.S. Bio-fabrication of Selenium Nanoparticles Using Baker’s Yeast Extract and Its Antimicrobial Efficacy on Food Borne Pathogens. Appl. Biochem. Biotechnol. 2022, 194, 1898–1910. [Google Scholar] [CrossRef]
- Salem, S.S.; Fouda, A. Green Synthesis of Metallic Nanoparticles and Their Prospective Biotechnological Applications: An Overview. Biol. Trace Elem. Res. 2021, 199, 344–370. [Google Scholar] [CrossRef]
- Sharaf, M.H.; Nagiub, A.M.; Salem, S.S.; Kalaba, M.H.; El Fakharany, E.M.; Abd El-Wahab, H. A new strategy to integrate silver nanowires with waterborne coating to improve their antimicrobial and antiviral properties. Pigment. Resin Technol. 2022. [Google Scholar] [CrossRef]
- Eid, A.M.; Fouda, A.; Niedbała, G.; Hassan, S.E.D.; Salem, S.S.; Abdo, A.M.; Hetta, H.F.; Shaheen, T.I. Endophytic streptomyces laurentii mediated green synthesis of Ag-NPs with antibacterial and anticancer properties for developing functional textile fabric properties. Antibiotics 2020, 9, 641. [Google Scholar] [CrossRef]
- Okba, M.M.; Baki, P.M.A.; Abu-Elghait, M.; Shehabeldine, A.M.; El-Sherei, M.M.; Khaleel, A.E.; Salem, M.A. UPLC-ESI-MS/MS profiling of the underground parts of common Iris species in relation to their anti-virulence activities against Staphylococcus aureus. J. Ethnopharmacol. 2022, 282, 114658. [Google Scholar] [CrossRef]
- Hasanin, M.; Al Abboud, M.A.; Alawlaqi, M.M.; Abdelghany, T.M.; Hashem, A.H. Ecofriendly Synthesis of Biosynthesized Copper Nanoparticles with Starch-Based Nanocomposite: Antimicrobial, Antioxidant, and Anticancer Activities. Biol. Trace Elem. Res. 2021, 200, 2099–2112. [Google Scholar] [CrossRef] [PubMed]
- Hasanin, M.; Hashem, A.H.; Lashin, I.; Hassan, S.A.M. In vitro improvement and rooting of banana plantlets using antifungal nanocomposite based on myco-synthesized copper oxide nanoparticles and starch. Biomass Convers. Biorefinery 2021. [Google Scholar] [CrossRef]
- Hashem, A.H.; Abdelaziz, A.M.; Askar, A.A.; Fouda, H.M.; Khalil, A.M.A.; Abd-Elsalam, K.A.; Khaleil, M.M. Bacillus megaterium-Mediated Synthesis of Selenium Nanoparticles and Their Antifungal Activity against Rhizoctonia solani in Faba Bean Plants. J. Fungi 2021, 7, 195. [Google Scholar] [CrossRef] [PubMed]
- Hashem, A.H.; Al Abboud, M.A.; Alawlaqi, M.M.; Abdelghany, T.M.; Hasanin, M. Synthesis of Nanocapsules Based on Biosynthesized Nickel Nanoparticles and Potato Starch: Antimicrobial, Antioxidant and Anticancer Activity. Starch-Stärke 2022, 74, e2100165. [Google Scholar] [CrossRef]
- Hashem, A.H.; Khalil, A.M.A.; Reyad, A.M.; Salem, S.S. Biomedical applications of mycosynthesized selenium nanoparticles using Penicillium expansum ATTC 36200. Biol. Trace Elem. Res. 2021, 199, 3998–4008. [Google Scholar] [CrossRef]
- Lashin, I.; Hasanin, M.; Hassan, S.A.M.; Hashem, A.H. Green biosynthesis of zinc and selenium oxide nanoparticles using callus extract of Ziziphus spina-christi: Characterization, antimicrobial, and antioxidant activity. Biomass Convers. Biorefinery 2021. [Google Scholar] [CrossRef]
- Hashem, A.H.; Salem, S.S. Green and ecofriendly biosynthesis of selenium nanoparticles using Urtica dioica (stinging nettle) leaf extract: Antimicrobial and anticancer activity. Biotechnol. J. 2022, 17, 2100432. [Google Scholar] [CrossRef]
- Singh, A.; Gautam, P.K.; Verma, A.; Singh, V.; Shivapriya, P.M.; Shivalkar, S.; Sahoo, A.K.; Samanta, S.K. Green synthesis of metallic nanoparticles as effective alternatives to treat antibiotics resistant bacterial infections: A review. Biotechnol. Rep. 2020, 25, e00427. [Google Scholar] [CrossRef]
- Al-Rajhi, A.M.H.; Salem, S.S.; Alharbi, A.A.; Abdelghany, T.M. Ecofriendly synthesis of silver nanoparticles using Kei-apple (Dovyalis caffra) fruit and their efficacy against cancer cells and clinical pathogenic microorganisms. Arab. J. Chem. 2022, 15, 103927. [Google Scholar] [CrossRef]
- Salem, S.S.; El-Belely, E.F.; Niedbała, G.; Alnoman, M.M.; Hassan, S.E.D.; Eid, A.M.; Shaheen, T.I.; Elkelish, A.; Fouda, A. Bactericidal and in-vitro cytotoxic efficacy of silver nanoparticles (Ag-NPs) fabricated by endophytic actinomycetes and their use as coating for the textile fabrics. Nanomaterials 2020, 10, 2082. [Google Scholar] [CrossRef]
- Kim, H.S.; Sun, X.; Lee, J.-H.; Kim, H.-W.; Fu, X.; Leong, K.W. Advanced drug delivery systems and artificial skin grafts for skin wound healing. Adv. Drug Deliv. Rev. 2019, 146, 209–239. [Google Scholar] [CrossRef] [PubMed]
- Tavares, T.D.; Antunes, J.C.; Padrão, J.; Ribeiro, A.I.; Zille, A.; Amorim, M.T.P.; Ferreira, F.; Felgueiras, H.P. Activity of specialized biomolecules against gram-positive and gram-negative bacteria. Antibiotics 2020, 9, 314. [Google Scholar] [CrossRef] [PubMed]
- Dumitrache, A. Understanding Biofilms of Anaerobic, Thermophilic and Cellulolytic Bacteria: A Study towards the Advancement of Consolidated Bioprocessing Strategies. Doctoral Dissertation, University of Toronto, Toronto, ON, Canada, 2014. [Google Scholar]
- Li, J.; Fu, J.; Tian, X.; Hua, T.; Poon, T.; Koo, M.; Chan, W. Characteristics of chitosan fiber and their effects towards improvement of antibacterial activity. Carbohydr. Polym. 2022, 280, 119031. [Google Scholar] [CrossRef] [PubMed]
- Wang, W.; Meng, Q.; Li, Q.; Liu, J.; Zhou, M.; Jin, Z.; Zhao, K. Chitosan derivatives and their application in biomedicine. Int. J. Mol. Sci. 2020, 21, 487. [Google Scholar] [CrossRef] [Green Version]
- Wei, S.; Ching, Y.C.; Chuah, C.H. Synthesis of chitosan aerogels as promising carriers for drug delivery: A review. Carbohydr. Polym. 2020, 231, 115744. [Google Scholar] [CrossRef]
- Saad, E.M.; Elshaarawy, R.F.; Mahmoud, S.A.; El-Moselhy, K.M. New Ulva lactuca Algae Based Chitosan Bio-composites for Bioremediation of Cd(II) Ions. J. Bioresour. Bioprod. 2021, 6, 223–242. [Google Scholar] [CrossRef]
- Almalik, A.; Benabdelkamel, H.; Masood, A.; Alanazi, I.O.; Alradwan, I.; Majrashi, M.A.; Alfadda, A.A.; Alghamdi, W.M.; Alrabiah, H.; Tirelli, N. Hyaluronic acid coated chitosan nanoparticles reduced the immunogenicity of the formed protein corona. Sci. Rep. 2017, 7, 10542. [Google Scholar] [CrossRef]
- Tekie, F.S.M.; Hajiramezanali, M.; Geramifar, P.; Raoufi, M.; Dinarvand, R.; Soleimani, M.; Atyabi, F. Controlling evolution of protein corona: A prosperous approach to improve chitosan-based nanoparticle biodistribution and half-life. Sci. Rep. 2020, 10, 9664. [Google Scholar] [CrossRef]
- Gonzalez, A.C.d.O.; Costa, T.F.; Andrade, Z.d.A.; Medrado, A.R.A.P. Wound healing-A literature review. An. Bras. De Dermatol. 2016, 91, 614–620. [Google Scholar] [CrossRef] [Green Version]
- Verma, J.; Kanoujia, J.; Parashar, P.; Tripathi, C.B.; Saraf, S.A. Wound healing applications of sericin/chitosan-capped silver nanoparticles incorporated hydrogel. Drug Deliv. Transl. Res. 2017, 7, 77–88. [Google Scholar] [CrossRef]
- Zhao, Y.; Li, Z.; Song, S.; Yang, K.; Liu, H.; Yang, Z.; Wang, J.; Yang, B.; Lin, Q. Skin-inspired antibacterial conductive hydrogels for epidermal sensors and diabetic foot wound dressings. Adv. Funct. Mater. 2019, 29, 1901474. [Google Scholar] [CrossRef]
- Dara, P.K.; Mahadevan, R.; Digita, P.A.; Visnuvinayagam, S.; Kumar, L.R.G.; Mathew, S.; Ravishankar, C.N.; Anandan, R. Synthesis and biochemical characterization of silver nanoparticles grafted chitosan (Chi-Ag-NPs): In vitro studies on antioxidant and antibacterial applications. SN Appl. Sci. 2020, 2, 665. [Google Scholar] [CrossRef] [Green Version]
- Shehabeldine, A.M.; Elbahnasawy, M.A.; Hasaballah, A.I. Green Phytosynthesis of Silver Nanoparticles Using Echinochloa stagnina Extract with Reference to Their Antibacterial, Cytotoxic, and Larvicidal Activities. BioNanoScience 2021, 11, 526–538. [Google Scholar] [CrossRef]
- Fouda, A.; Khalil, A.; El-Sheikh, H.; Abdel-Rhaman, E.; Hashem, A. Biodegradation and detoxification of bisphenol-A by filamentous fungi screened from nature. J. Adv. Biol. Biotechnol. 2015, 2, 123–132. [Google Scholar] [CrossRef]
- Hashem, A.H.; Hasanin, M.S.; Khalil, A.M.A.; Suleiman, W.B. Eco-green conversion of watermelon peels to single cell oils using a unique oleaginous fungus: Lichtheimia corymbifera AH13. Waste Biomass Valorization 2019, 11, 5721–5732. [Google Scholar] [CrossRef]
- Suleiman, W.; El-Sheikh, H.; Abu-Elreesh, G.; Hashem, A. Recruitment of Cunninghamella echinulata as an Egyptian isolate to produce unsaturated fatty acids. Res. J. Pharm. Biol. Chem. Sci. 2018, 9, 764–774. [Google Scholar]
- Suleiman, W.; El-Skeikh, H.; Abu-Elreesh, G.; Hashem, A. Isolation and screening of promising oleaginous Rhizopus sp and designing of Taguchi method for increasing lipid production. J. Innov. Pharm. Biol. Sci. 2018, 5, 8–15. [Google Scholar]
- Elshikh, M.; Ahmed, S.; Funston, S.; Dunlop, P.; McGaw, M.; Marchant, R.; Banat, I.M. Resazurin-based 96-well plate microdilution method for the determination of minimum inhibitory concentration of biosurfactants. Biotechnol. Lett. 2016, 38, 1015–1019. [Google Scholar] [CrossRef] [Green Version]
- Chakansin, C.; Yostaworakul, J.; Warin, C.; Kulthong, K.; Boonrungsiman, S. Resazurin rapid screening for antibacterial activities of organic and inorganic nanoparticles: Potential, limitations and precautions. Anal. Biochem. 2022, 637, 114449. [Google Scholar] [CrossRef]
- Sawasdidoln, C.; Taweechaisupapong, S.; Sermswan, R.W.; Tattawasart, U.; Tungpradabkul, S.; Wongratanacheewin, S. Growing Burkholderia pseudomallei in biofilm stimulating conditions significantly induces antimicrobial resistance. PLoS ONE 2010, 5, e9196. [Google Scholar] [CrossRef] [Green Version]
- Tofiño-Rivera, A.; Ortega-Cuadros, M.; Galvis-Pareja, D.; Jiménez-Rios, H.; Merini, L.J.; Martínez-Pabón, M.C. Effect of Lippia alba and Cymbopogon citratus essential oils on biofilms of Streptococcus mutans and cytotoxicity in CHO cells. J. Ethnopharmacol. 2016, 194, 749–754. [Google Scholar] [CrossRef] [PubMed] [Green Version]
- Shehabeldine, A.M.; Ashour, R.M.; Okba, M.M.; Saber, F.R. Callistemon citrinus bioactive metabolites as new inhibitors of methicillin-resistant Staphylococcus aureus biofilm formation. J. Ethnopharmacol. 2020, 254, 112669. [Google Scholar] [CrossRef] [PubMed]
- Chaieb, K.; Kouidhi, B.; Jrah, H.; Mahdouani, K.; Bakhrouf, A. Antibacterial activity of Thymoquinone, an active principle of Nigella sativa and its potency to prevent bacterial biofilm formation. BMC Complementary Altern. Med. 2011, 11, 29. [Google Scholar] [CrossRef] [PubMed] [Green Version]
- Clinical and Laboratory Standards Institute. Reference Method for Broth Dilution Antifungal Susceptibility Testing of Yeasts; National Committee for Clinical Laboratory Standards: Wayne, PA, USA, 2002. [Google Scholar]
- Khalil, A.M.A.; Abdelaziz, A.M.; Khaleil, M.M.; Hashem, A.H. Fungal endophytes from leaves of Avicennia marina growing in semi-arid environment as a promising source for bioactive compounds. Lett. Appl. Microbiol. 2020, 72, 263–274. [Google Scholar] [CrossRef]
- Khalil, A.M.A.; Hashem, A.H. Morphological changes of conidiogenesis in two aspergillus species. J. Pure Appl. Microbiol. 2018, 12, 2041–2048. [Google Scholar] [CrossRef] [Green Version]
- Khalil, A.M.A.; Hashem, A.H.; Abdelaziz, A.M. Occurrence of toxigenic Penicillium polonicum in retail green table olives from the Saudi Arabia market. Biocatal. Agric. Biotechnol. 2019, 21, 101314. [Google Scholar] [CrossRef]
- Shehabeldine, A.; El-Hamshary, H.; Hasanin, M.; El-Faham, A.; Al-Sahly, M. Enhancing the Antifungal Activity of Griseofulvin by Incorporation a Green Biopolymer-Based Nanocomposite. Polymers 2021, 13, 542. [Google Scholar] [CrossRef]
- Dacrory, S.; Hashem, A.H.; Hasanin, M. Synthesis of cellulose based amino acid functionalized nano-biocomplex: Characterization, antifungal activity, molecular docking and hemocompatibility. Environ. Nanotechnol. Monit. Manag. 2021, 15, 100453. [Google Scholar] [CrossRef]
- Vajrabhaya, L.-O.; Korsuwannawong, S. Cytotoxicity evaluation of a Thai herb using tetrazolium (MTT) and sulforhodamine B (SRB) assays. J. Anal. Sci. Technol. 2018, 9, 15. [Google Scholar] [CrossRef] [Green Version]
- Orellana, E.A.; Kasinski, A.L. Sulforhodamine B (SRB) assay in cell culture to investigate cell proliferation. Bio-Protocol 2016, 6, e1984. [Google Scholar] [CrossRef] [Green Version]
- Houdkova, M.; Urbanova, K.; Doskocil, I.; Soon, J.W.; Foliga, T.; Novy, P.; Kokoska, L. Anti-staphylococcal activity, cytotoxicity, and chemical composition of hexane extracts from arils and seeds of two Samoan Myristica spp. South Afr. J. Bot. 2021, 139, 1–5. [Google Scholar] [CrossRef]
- Rameshk, M.; Sharififar, F.; Mehrabani, M.; Pardakhty, A.; Farsinejad, A.; Mehrabani, M. Proliferation and in vitro wound healing effects of the Microniosomes containing Narcissus tazetta L. bulb extract on primary human fibroblasts (HDFs). DARU J. Pharm. Sci. 2018, 26, 31–42. [Google Scholar] [CrossRef] [PubMed]
- Alshalal, I.A.R. Development of In Vitro Models to Investigate the Role of Decidualisation, PDGF, and ho-1 on Stromal–Trophoblast Interaction. Doctoral Dissertation, University of Birmingham, Birmingham, UK, 2020. [Google Scholar]
- Grada, A.; Otero-Vinas, M.; Prieto-Castrillo, F.; Obagi, Z.; Falanga, V. Research techniques made simple: Analysis of collective cell migration using the wound healing assay. J. Investig. Dermatol. 2017, 137, e11–e16. [Google Scholar] [CrossRef] [PubMed] [Green Version]
- Mourdikoudis, S.; Pallares, R.M.; Thanh, N.T. Characterization techniques for nanoparticles: Comparison and complementarity upon studying nanoparticle properties. Nanoscale 2018, 10, 12871–12934. [Google Scholar] [CrossRef] [Green Version]
- Alshehri, M.A.; Trivedi, S.; Panneerselvam, C. Efficacy of chitosan silver nanoparticles from shrimp-shell wastes against major mosquito vectors of public health importance. Green Processing Synth. 2020, 9, 675–684. [Google Scholar] [CrossRef]
- Shehabeldine, A.; Hasanin, M. Green synthesis of hydrolyzed starch–chitosan nano-composite as drug delivery system to gram negative bacteria. Environ. Nanotechnol. Monit. Manag. 2019, 12, 100252. [Google Scholar] [CrossRef]
- Venault, A.; Chen, S.-J.; Lin, H.-T.; Maggay, I.; Chang, Y. Bi-continuous positively-charged PVDF membranes formed by a dual-bath procedure with bacteria killing/release ability. Chem. Eng. J. 2021, 417, 128910. [Google Scholar] [CrossRef]
- Damm, C.; Münstedt, H.; Rösch, A. The antimicrobial efficacy of polyamide 6/silver-nano-and microcomposites. Mater. Chem. Phys. 2008, 108, 61–66. [Google Scholar] [CrossRef]
- Gurunathan, S.; Han, J.W.; Kwon, D.-N.; Kim, J.-H. Enhanced antibacterial and anti-biofilm activities of silver nanoparticles against Gram-negative and Gram-positive bacteria. Nanoscale Res. Lett. 2014, 9, 373. [Google Scholar] [CrossRef] [Green Version]
- Barabadi, H.; Mohammadzadeh, A.; Vahidi, H.; Rashedi, M.; Saravanan, M.; Talank, N.; Alizadeh, A. Penicillium chrysogenum-derived silver nanoparticles: Exploration of their antibacterial and biofilm inhibitory activity against the standard and pathogenic Acinetobacter baumannii compared to tetracycline. J. Clust. Sci. 2021, 1–14. [Google Scholar] [CrossRef]
- Ferreiraa, M.R.; Gomesa, S.C.; Moreiraa, L.M. Mucoid switch in Burkholderia cepacia complex bacteria: Triggers, molecular mechanisms and implications in pathogenesis. Adv. Appl. Microbiol. 2019, 107, 113–140. [Google Scholar]
- Rajivgandhi, G.N.; Maruthupandy, M.; Li, J.-L.; Dong, L.; Alharbi, N.S.; Kadaikunnan, S.; Khaled, J.M.; Alanzi, K.F.; Li, W.-J. Photocatalytic reduction and anti-bacterial activity of biosynthesized silver nanoparticles against multi drug resistant Staphylococcus saprophyticus BDUMS 5 (MN310601). Mater. Sci. Eng. C 2020, 114, 111024. [Google Scholar] [CrossRef] [PubMed]
- Bao, V.-V.Q.; Vuong, L.D.; Waché, Y. Synthesis of chitosan–silver nanoparticles with antifungal properties on bamboo straws. Nanomater. Energy 2021, 10, 111–117. [Google Scholar] [CrossRef]
- Shrifian-Esfahni, A.; Salehi, M.T.; Nasr-Esfahni, M.; Ekramian, E. Chitosan-modified superparamgnetic iron oxide nanoparticles: Design, fabrication, characterization and antibacterial activity. Chemik 2015, 69, 19–32. [Google Scholar]
- Phaniendra, A.; Jestadi, D.B.; Periyasamy, L. Free radicals: Properties, sources, targets, and their implication in various diseases. Indian J. Clin. Biochem. 2015, 30, 11–26. [Google Scholar] [CrossRef] [Green Version]
- Rehana, D.; Mahendiran, D.; Kumar, R.S.; Rahiman, A.K. Evaluation of antioxidant and anticancer activity of copper oxide nanoparticles synthesized using medicinally important plant extracts. Biomed. Pharmacother. 2017, 89, 1067–1077. [Google Scholar] [CrossRef]
- Nunes, M.R.; de Souza Maguerroski Castilho, M.; de Lima Veeck, A.P.; da Rosa, C.G.; Noronha, C.M.; Maciel, M.V.O.B.; Barreto, P.M. Antioxidant and antimicrobial methylcellulose films containing Lippia alba extract and silver nanoparticles. Carbohydr. Polym. 2018, 192, 37–43. [Google Scholar] [CrossRef]
- Hu, Y.-L.; Qi, W.; Han, F.; Shao, J.-Z.; Gao, J.-Q. Toxicity evaluation of biodegradable chitosan nanoparticles using a zebrafish embryo model. Int. J. Nanomed. 2011, 6, 3351. [Google Scholar]
- Mishra, V.; Nayak, P.; Singh, M.; Tambuwala, M.M.; Aljabali, A.A.; Chellappan, D.K.; Dua, K. Pharmaceutical aspects of green synthesized silver nanoparticles: A boon to cancer treatment. Anti-Cancer Agents Med. Chem. 2021, 21, 1490–1509. [Google Scholar] [CrossRef]
- Croisier, F.; Jérôme, C. Chitosan-based biomaterials for tissue engineering. Eur. Polym. J. 2013, 49, 780–792. [Google Scholar] [CrossRef] [Green Version]
- Hajji, S.; Khedir, S.B.; Hamza-Mnif, I.; Hamdi, M.; Jedidi, I.; Kallel, R.; Boufi, S.; Nasri, M. Biomedical potential of chitosan-silver nanoparticles with special reference to antioxidant, antibacterial, hemolytic and in vivo cutaneous wound healing effects. Biochim. Biophys. Acta (BBA)-Gen. Subj. 2019, 1863, 241–254. [Google Scholar] [CrossRef] [PubMed]
- Souto, E.B.; Ribeiro, A.F.; Ferreira, M.I.; Teixeira, M.C.; Shimojo, A.A.; Soriano, J.L.; Naveros, B.C.; Durazzo, A.; Lucarini, M.; Souto, S.B. New nanotechnologies for the treatment and repair of skin burns infections. Int. J. Mol. Sci. 2020, 21, 393. [Google Scholar] [CrossRef] [PubMed] [Green Version]

| MIC µg/mL | MBC µg/mL | |||
|---|---|---|---|---|
| Ag+ | 25.0 | 50.0 | 100.0 | ND |
| Chi | 50.0 | 100.0 | 100.0 | ND |
| Chi/AgNPs | 12.5 | 12.5 | 25.0 | 50.0 |
| Organisms | C. albicans | A. fumgatus | A. terreus | A. niger | ||||
|---|---|---|---|---|---|---|---|---|
| Materials | IZ/mm (4000 µg/mL) | MIC µg/mL | IZ/mm (4000 µg/mL) | MIC µg/mL | IZ/mm (4000 µg/mL) | MIC µg/mL | IZ/mm (4000 µg/mL) | MIC µg/mL |
| Chi | Nil | ND | 8.00 | 4000 | Nil | ND | Nil | ND |
| Ag+ | 16.00 | 1000 | Nil | ND | Nil | ND | 8.00 | 4000 |
| Chi/Ag-NPs | 22.00 | 250 | 29.00 | 62.5 | 20.00 | 500 | 17.00 | 1000 |
| NS | 21.00 | 250 | 10.00 | 2000 | 8.00 | 4000 | 9.00 | 4000 |
Publisher’s Note: MDPI stays neutral with regard to jurisdictional claims in published maps and institutional affiliations. |
© 2022 by the authors. Licensee MDPI, Basel, Switzerland. This article is an open access article distributed under the terms and conditions of the Creative Commons Attribution (CC BY) license (https://creativecommons.org/licenses/by/4.0/).
Share and Cite
Shehabeldine, A.M.; Salem, S.S.; Ali, O.M.; Abd-Elsalam, K.A.; Elkady, F.M.; Hashem, A.H. Multifunctional Silver Nanoparticles Based on Chitosan: Antibacterial, Antibiofilm, Antifungal, Antioxidant, and Wound-Healing Activities. J. Fungi 2022, 8, 612. https://doi.org/10.3390/jof8060612
Shehabeldine AM, Salem SS, Ali OM, Abd-Elsalam KA, Elkady FM, Hashem AH. Multifunctional Silver Nanoparticles Based on Chitosan: Antibacterial, Antibiofilm, Antifungal, Antioxidant, and Wound-Healing Activities. Journal of Fungi. 2022; 8(6):612. https://doi.org/10.3390/jof8060612
Chicago/Turabian StyleShehabeldine, Amr M., Salem S. Salem, Omar M. Ali, Kamel A. Abd-Elsalam, Fathy M. Elkady, and Amr H. Hashem. 2022. "Multifunctional Silver Nanoparticles Based on Chitosan: Antibacterial, Antibiofilm, Antifungal, Antioxidant, and Wound-Healing Activities" Journal of Fungi 8, no. 6: 612. https://doi.org/10.3390/jof8060612
APA StyleShehabeldine, A. M., Salem, S. S., Ali, O. M., Abd-Elsalam, K. A., Elkady, F. M., & Hashem, A. H. (2022). Multifunctional Silver Nanoparticles Based on Chitosan: Antibacterial, Antibiofilm, Antifungal, Antioxidant, and Wound-Healing Activities. Journal of Fungi, 8(6), 612. https://doi.org/10.3390/jof8060612










